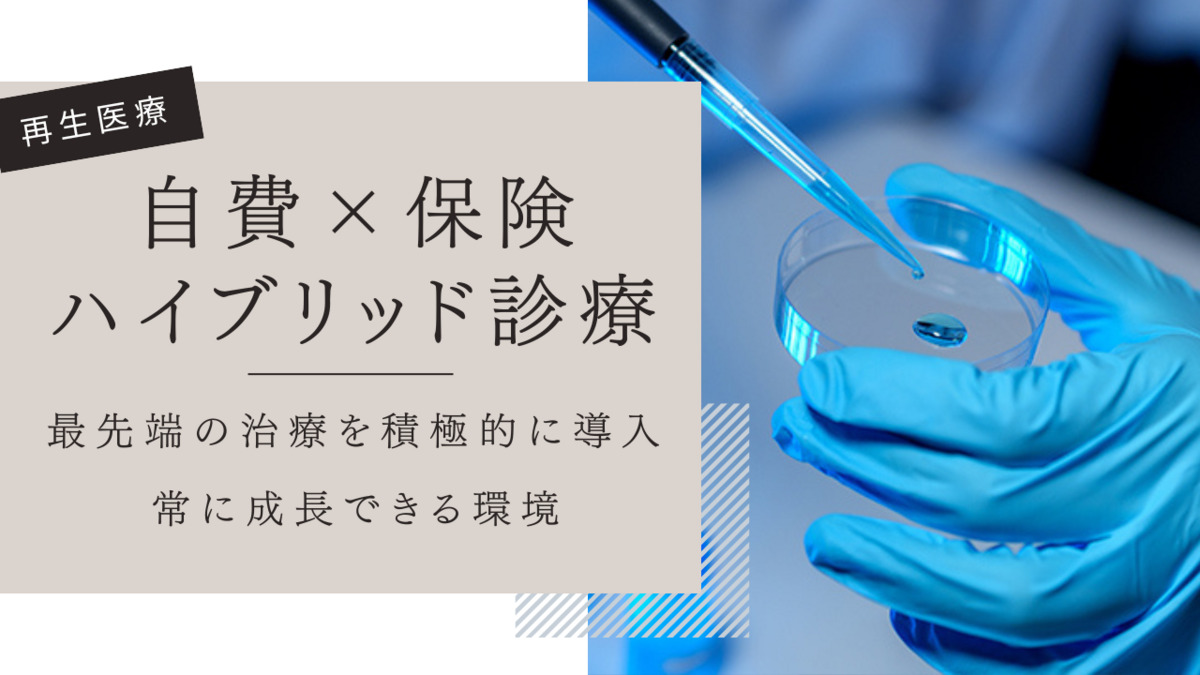
SBC横浜駅前整形外科クリニック【2025年06月09日オープン】（理学療法士の求人）の写真2枚目：

【横浜駅徒歩3分/6月9日開院】賞与年2回・プチボーナス年4回・基本定時退社・最大10連休OK・福利厚生充実◎
SBC横浜駅前整形外科クリニックのご紹介
2025年現在、国内外に200院以上を展開するSBCメディカルグループが運営。2025年6月9日に新規開院した当院はメインである整形外科の保険診療のほか、関節の再生医療などの自費診療にも力をいれております。
リハビリテーション科は担当・予約制で、ひとりひとりの症状に合わせたリハビリテーションや日常生活のアドバイスを積極的に行なっています。
理学療法士の在籍数:4名
理学療法士の年齢層:20~30代
■-■-■-■-■-■-■-■-■-■-■
『自分の成長』に応じて年収UPが目指せます
月給28~32万(経験年数に応じて入社時の給与を決定いたします)
賞与年2回、昇給年1回査定あり、プチボーナス年4回
人事評価制度を導入しておりますので、自分の頑張りや成長がしっかり評価される環境です
■-■-■-■-■-■-■-■-■-■-■
20種類以上の充実した福利厚生
★人気1位家賃補助制度
★人気2位
お勉強休暇(研修中に6日分付与されるお休みです)
★人気3位
飲みニケーション(お食事代は会社負担)
※福利厚生は社内規定あり(対象時期など)
■-■-■-■-■-■-■-■-■-■-■
充実した研修制度・学ぶ環境
研修中はプリセプターと呼ばれる先輩スタッフが1:1でサポートします。分からないことや不安なことがあればすぐに聞ける環境なので理学療法士経験が浅い方もご安心ください!
また、定期的に理学療法士同士でミーティングを開催し、それぞれの知識や技術のシェアをしたり勉強会を行なうなど、幅広いスキルを身につけるチャンスがあります。
■-■-■-■-■-■-■-■-■-■-■
このような方が向いています!
・再生医療に携わりたい方・新たな分野にチャレンジしたい方
・幅広いスキルを身につけたい方
・向上心のある方
・チームワークを大切にしている方
■-■-■-■-■-■-■-■-■-■-■
院の雰囲気
穏やかなスタッフが多く、アットホームな雰囲気のクリニックです。他者の意見を尊重しながら活発に意見交換や解決案を出し合ってクリニックの改善ができるチームです。
チームワークを大切にする方や、問題解決意識の高い方がよりマッチしやすいです。
■-■-■-■-■-■-■-■-■-■-■
院長のお人柄
三浪 友輔 院長は温厚で患者様に親身に寄り添った対応をされる先生です。先生のお人柄がクリニックにも影響しアットホームで親しみやすい雰囲気を作っています。
■-■-■-■-■-■-■-■-■-■-■
院内見学も大歓迎なので気になる方は是非見学にお越しください
募集内容
募集職種
仕事内容
・物理療法含めた臨床業務 ・カルテ記載、書類作成、SNS(Instagram)の更新 ・カンファレンス ・お客様への再生医療の提案 ・次回予約などの事務作業 ・掃除、洗濯 ▼カンファレンス 月2回実施。 医師、理学療法士(全員)、看護師、受付が参加。 お客様の身体状況の確認や再生医療対象者の共有と治療方針を協議し情報交換を行っています。 ▼再生医療について 再生医療を導入しており、最先端の治療を学ぶことができます。 再生医療の効果を最大限に引き出すために治療前後のリハビリテーションを組み合わせ、相乗効果を図ります。 そのため定期的に勉強会や医師・看護師とカンファレンスを行ない情報交換をしながら協力して治療をすすめています。 【1日の流れ(例)】 9:00 朝礼、業務準備 9:15 リハビリ業務、カルテ記載 13:00 予約状況により交代で休憩 14:00 リハビリ業務、カルテ記載 17:45 カルテ記載、掃除 18:00 業務終了
診療科目・ サービス形態
給与
給与の備考
実務経験によって、給与が異なります。 ・通勤手当 上限30,000円/月 ・賞与年2回(7月・12月) ∟本採用後から支給、算定都合上初年度は満額支給無し ・昇給査定あり(年1回/4月) ・短期業績手当年4回(2月、5月、8月、11月) ∟本採用1年後より支給 ・固定残業代なし(残業が発生した場合も1分単位で支給) 試用期間:6ヶ月 試用期間:6ヶ月 期間中は有期雇用契約 期間中も給与変動なし 【モデル年収】 ▸実務経験2年で入職した場合 ・3年目:年収 約400万円 ・5年目:年収 約415万円 ・10年目:年収 約460万円 ▸実務経験4年で入職した場合 ・3年目:年収 約460万円 ・5年目:年収 約470万円 ・10年目:年収 約520万円
待遇
■福利厚生(社労士監修) ・社会保険完備(雇用・労災・健康・厚生年金) ・家賃補助制度 ※本採用1年後より適用(規定あり) ・飲みニケーション制度(2ヵ月に1回) ・部活動 ・定期健康診断 ・インフルエンザ予防接種 ・祝勝会 ・My Star/SBC AWARD(社内表彰制度) ・制服貸与 ・退職金制度(勤続3年以上) ・企業型確定拠出年金制度 ・確定給付企業年金制度 ・キャリアリターン制度 (正社員→パート→正社員(一部実績継続))※規定あり ▼働く女性や子育てを支援する制度 ・保育料支援制度 (保育料基本金額の50%・上限2万円) ※本採用1年後より適用 ・育児短時間勤務制度 (労働時間を1~2時間短縮) ※3才未満・入社1年以上(規定あり) ・採卵・卵子凍結支援制度 (六本木レディースクリニックで対応) ※本採用後より適用 ・ベビーシッター制度 ※3才~就学前・入社1年以上(規定あり) ・アーリーバード制度 (役職者限定・保育園お迎えのための早出) ※子が6才になるまで ▼その他 ・社員割引あり ・副業可(社内規定あり) ※各種規定あり
教育体制・研修
~集合研修(2日間)~ 東京で行われる座学研修にて、理念やビジョン、事業などへの理解を深めます。 宿泊を伴う場合、宿泊費や交通費は会社が負担します。 ~配属先でのOJT研修(6ヶ月)~ 研修中はプリセプターと呼ばれる先輩スタッフが1:1でサポートします。 ▼研修の流れ(一例) ↓入職研修(座学) ↓変形性膝関節症 ↓腰部疾患 ↓首下がり症候群 ↓最終チェック ★研修修了! ~その他~ オンライン学習・内部研修:年次や役職など様々なタイミングで適宜開催 カンファレンス・勉強会:月2回実施
勤務時間
診療時間に準ずる(実働8時間/休憩1時間) 10:00~19:00(休診:木曜日) ※残業時間は月に1時間程度です
休日
・週休2日(シフト制/月9~10日) ・年間休日110日 ▶最大10連休OK(繁忙期を除く) ▶希望休は月3日までOK(土日・祝日もOK)
長期休暇・特別休暇
★初年度は、年間121日の休日取得が可能★ ∟年間休日110日+お勉強休暇6日+有給休暇5日(半年分) ・有給休暇(入社半年後10日間付与/その後1年毎に付与) ・慶弔休暇 ・介護休暇 ・産前産後休暇 ・産後パパ育休 ・育児休暇 ・子の看護等休暇 ・お勉強休暇6日(入社後すぐに利用可) ∟研修期間中に「ゆっくり勉強したい」「少し休みたい」というスタッフの声から生まれた制度です ・チャレンジ休暇(本採用後3年以上の方が対象/最長2か月) ∟「海外留学」「資格取得」を目的とした長期休暇 ※各種規定あり
応募要件
【必須】 ・理学療法士の実務経験がある方(年数不問)
歓迎要件
【歓迎】 ・実務経験2年以上の方 ・整形外科クリニックでの実務経験をお持ちの方
選考プロセス
(1)ジョブメドレーから応募 ▼ (2)WEB面接(1回)※見学も可 ▼ (3)内定 ●遠方の方もOK ●見学のみOK ●今すぐの転職でなくてもOK ●応募から内定までは1~2週間程度 ●原則、毎月1日入社 ●土日祝日の面接もOK
必要な情報を登録後、施設に直接電話ができます
電話応募画面へ進む写真
事業所情報
応募に関するよくある質問
会員登録をするとほかの医院・事業所からも自分の氏名などを閲覧できてしまうのでしょうか?
氏名と電話番号は、応募した医院・事業所以外からは閲覧できません。また、スカウト機能を「受け取らない」に設定していれば、それ以外のプロフィールも医院・事業所から閲覧できませんので、ご就業中の方も安心してご利用いただくことができます。詳しくはプライバシーポリシーをご確認ください。
応募を悩んでいる時は応募しないほうがいいですか?
事業所の雰囲気を知れるよい機会ですので興味を持った求人があればぜひ応募してみてください。
求人内容について質問をすることはできますか?
応募後、ジョブメドレーのメッセージ機能より、事業所に直接ご質問ください。求人内容についての質問は、ジョブメドレーからはお答えできかねます。
応募して質問する電話で応募したい場合はどうしたらよいでしょうか?
「電話応募画面へ進む」ボタンよりお問い合わせに必要な情報をご登録の上、お電話をおかけください。お電話の際は必ず「ジョブメドレーから応募した」旨をお伝えください。
電話応募画面へ進む